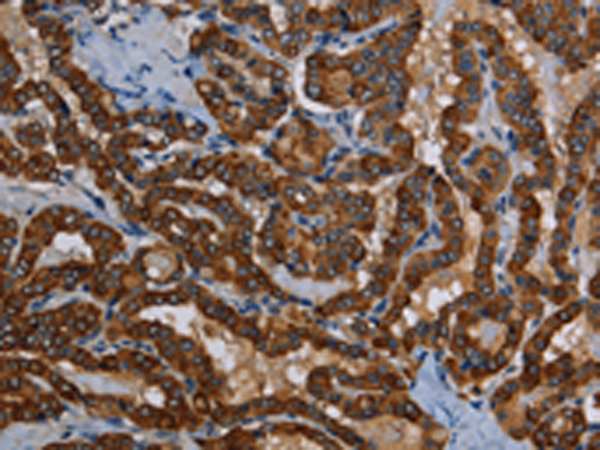

-
分类: 科研抗体货号: P08474别名: Mar7; BCUR1; Mart7应用: IHC反应种属: Human
-
分类: 科研抗体货号: P08451别名: JAM; KAT; JAM1; JAMA; JCAM; CD321; PAM-1应用: WB,IHC反应种属: Human
-
分类: 科研抗体货号: P08473别名: DLD应用: WB反应种属: Human
-
分类: 科研抗体货号: P08484别名: LRDD; PIDD应用: IHC反应种属: Human
-
分类: 科研抗体货号: P08472别名: CT32; LDH3; LDHX应用: WB,IHC反应种属: Human
-
分类: 科研抗体货号: P08483别名: LPL; CP64; PLS2; LC64P; HEL-S-37; L-PLASTIN应用: WB反应种属: Human, Mouse
-
分类: 科研抗体货号: P08471别名: PHA; LMN2R; TDRD18; DHCR14B应用: WB,IHC反应种属: Human
-
分类: 科研抗体货号: P08481别名:应用: IHC反应种属: Human, Mouse
-
分类: 科研抗体货号: P08500别名: MPD2; ALS21; VCPDM应用: WB反应种属: Human, Mouse
-
分类: 科研抗体货号: P08480别名: PINCH; PINCH1; PINCH-1应用: WB,IHC反应种属: Human, Mouse

鄂公网安备42018502007531号
鄂公网安备42018502007531号

